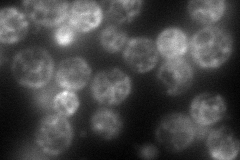

View description
GTPase with a role in ER morphology; interacts physically and genetically with Yop1p and Rtn1p; possible functional ortholog of mammalian atlastins, defects in which cause a form of hereditary spastic paraplegia; homolog of Arabidopsis RHD3
Localization:
Intensity:
Fold change:
Significance:
-
C’ GFP library in SD

punctate48.93 -
N' NOP1pr-GFP in SD
cytosol,ER,bud122.54 -
N' TEF2pr-mCherry in SD

cell periphery,punctate,bud161.659 -
N' NATIVEpr-GFP in SD

ER,punctate,bud34.7702 -
N' TEF2pr-VC and Cyto-VN in SD

punctate45.0877 -
C’ GFP library in SD+DTT

punctate52.941.08No -
C’ GFP library in SD+H2O2

punctate46.390.94No -
C’ GFP library in Starvation Media

punctate34.80.71No -
C’ GFP library on the background of Pup2-DaMP

punctate -
C’ GFP library on the background of CCT mutant

punctate54.11541.10583No
